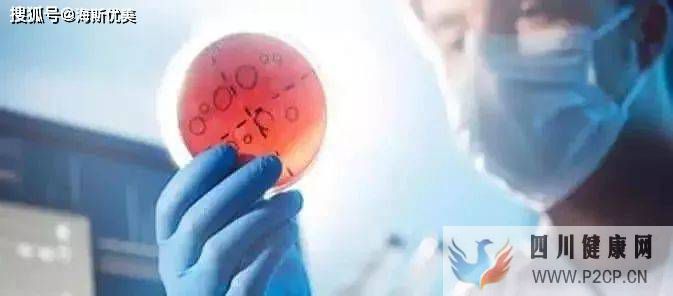
健康才有未来，干细胞对机体的保健干预(图2)

健康才有未来,干细胞对机体的保健干预
原标题:健康才有未来,干细胞对机体的保健干预
“人的问题就是细胞的问题,细胞的问题就交给细胞自己来处理”
“大力发展干细胞与免疫细胞疗法是全世界的趋势,也是人类医疗发展的必经之路!”
干细胞治疗一直是各国在生命科学前沿最重视的领域之一,受各国政府政策支持和新研究领域方法的推动,干细胞研究领域成为前沿热点。
目前干细胞技术主要由欧美等发达国家引领,美国、英国、加拿大、日本等国家优势突出;发展中国家在领域内有一定的差距,但整体差距不大,中国已进入全球干细胞治疗领域的第一梯队。

干细胞技术是攻克传统医学所不能及的重大疾病的一种全新医疗技术,是当今和未来再生医学的研究热点和发展方向,已被列入“人类十大科技进展”之首和国家重大科技专项。
基于干细胞的再生医学或组织再生治疗,干细胞技术是继药物治疗和手术治疗之后的又一次医疗技术革命,干细胞治疗在疾病的保健康复阶段具有更加重要的意义。
★ 干细胞保健干预 ★
亚健康调理
干细胞可帮助亚健康人群改善睡眠质量,迅速提升机体活力,增强体质,消除疲劳乏力体虚等症状。
美容抗衰
干细胞可清除衰老细胞,修复损伤细胞,促进气血循环,活化肌肤,使皮肤恢复弹性,减少皮肤皱纹和黑色素沉着,使机体恢复年轻状态。
防癌抗癌
干细胞可清除体内病变细胞,同时分泌大量的细胞诱导因子,促进细胞新生,调节代谢水平,防止癌症的发生。
★ 适合人群 ★
1.工作压力大,饮食不合理、作息不规律、长期抽烟、饮酒等亚健康人群;
2.头发早白、腰膝酸软、颈背部僵硬疼痛、失眠多梦等早衰人群;
3.身体肥胖、便秘腹泻、高血压、高血脂、高血糖等代谢异常人群;
4.皮肤松弛、皱纹增多、面部灰暗、乳房下垂、外部体征衰老等人群;
5.男女身体机能衰退、性能力衰退、性冷淡人群;
6.女性乳房肿块、子宫肌瘤、妇科炎症等妇科方面各种疾病人群;
7.心脑血管、泌尿、呼吸、消化等人体九大系统各种慢性疾病人群;
8.家族有疾病遗传史;
9.免疫功能低下,疾病手术后康复期及癌症高危人群;
10.追求身体机能年轻,外貌恢复年轻态,注重生活品质的高端人士。
★ 海斯医学★
海斯医学是央企新兴际华集团旗下海南海药(股票代码:)优尼科尔生物科技公司的全面战略合作伙伴,双方共建新兴际华海药细胞组织库西北分库、新兴际华海药细胞制备中心西北分中心和优尼海斯健康管理中心。
★ 产品及服务★
细胞存储与制备
免疫细胞存储
干细胞存储
细胞深低温存储技术研究
免疫细胞治疗技术
抗肿瘤免疫细胞新药研发
干细胞技术用于抗衰老
其它健管服务
美容及护肤品
医疗线护肤产品
居家日护产品
医美抗衰服务
海斯医学是一家立足医疗健康领域,以干细胞与再生医学研究及技术成果转化为核心的创新型高科技产业公司,可为客户提供“四位一体”(检测、预防、干预、康复)全生命周期闭环式健康管理服务。
自成立以来,海斯医学坚持与国际标准同步,聚集了细胞领域成果卓越的专家与国内外学者领衔的专业技术研发团队,凭借着先进的储备技术、严格的质量管理流程和优质的服务水平,保障客户的健康安全。
未来,海斯医学将围绕再生医学全产业链,严格执行质量管理标准,确保研发质量及服务水平提升,持续为客户提供最满意的服务。返回搜狐,查看更多
责任编辑:





